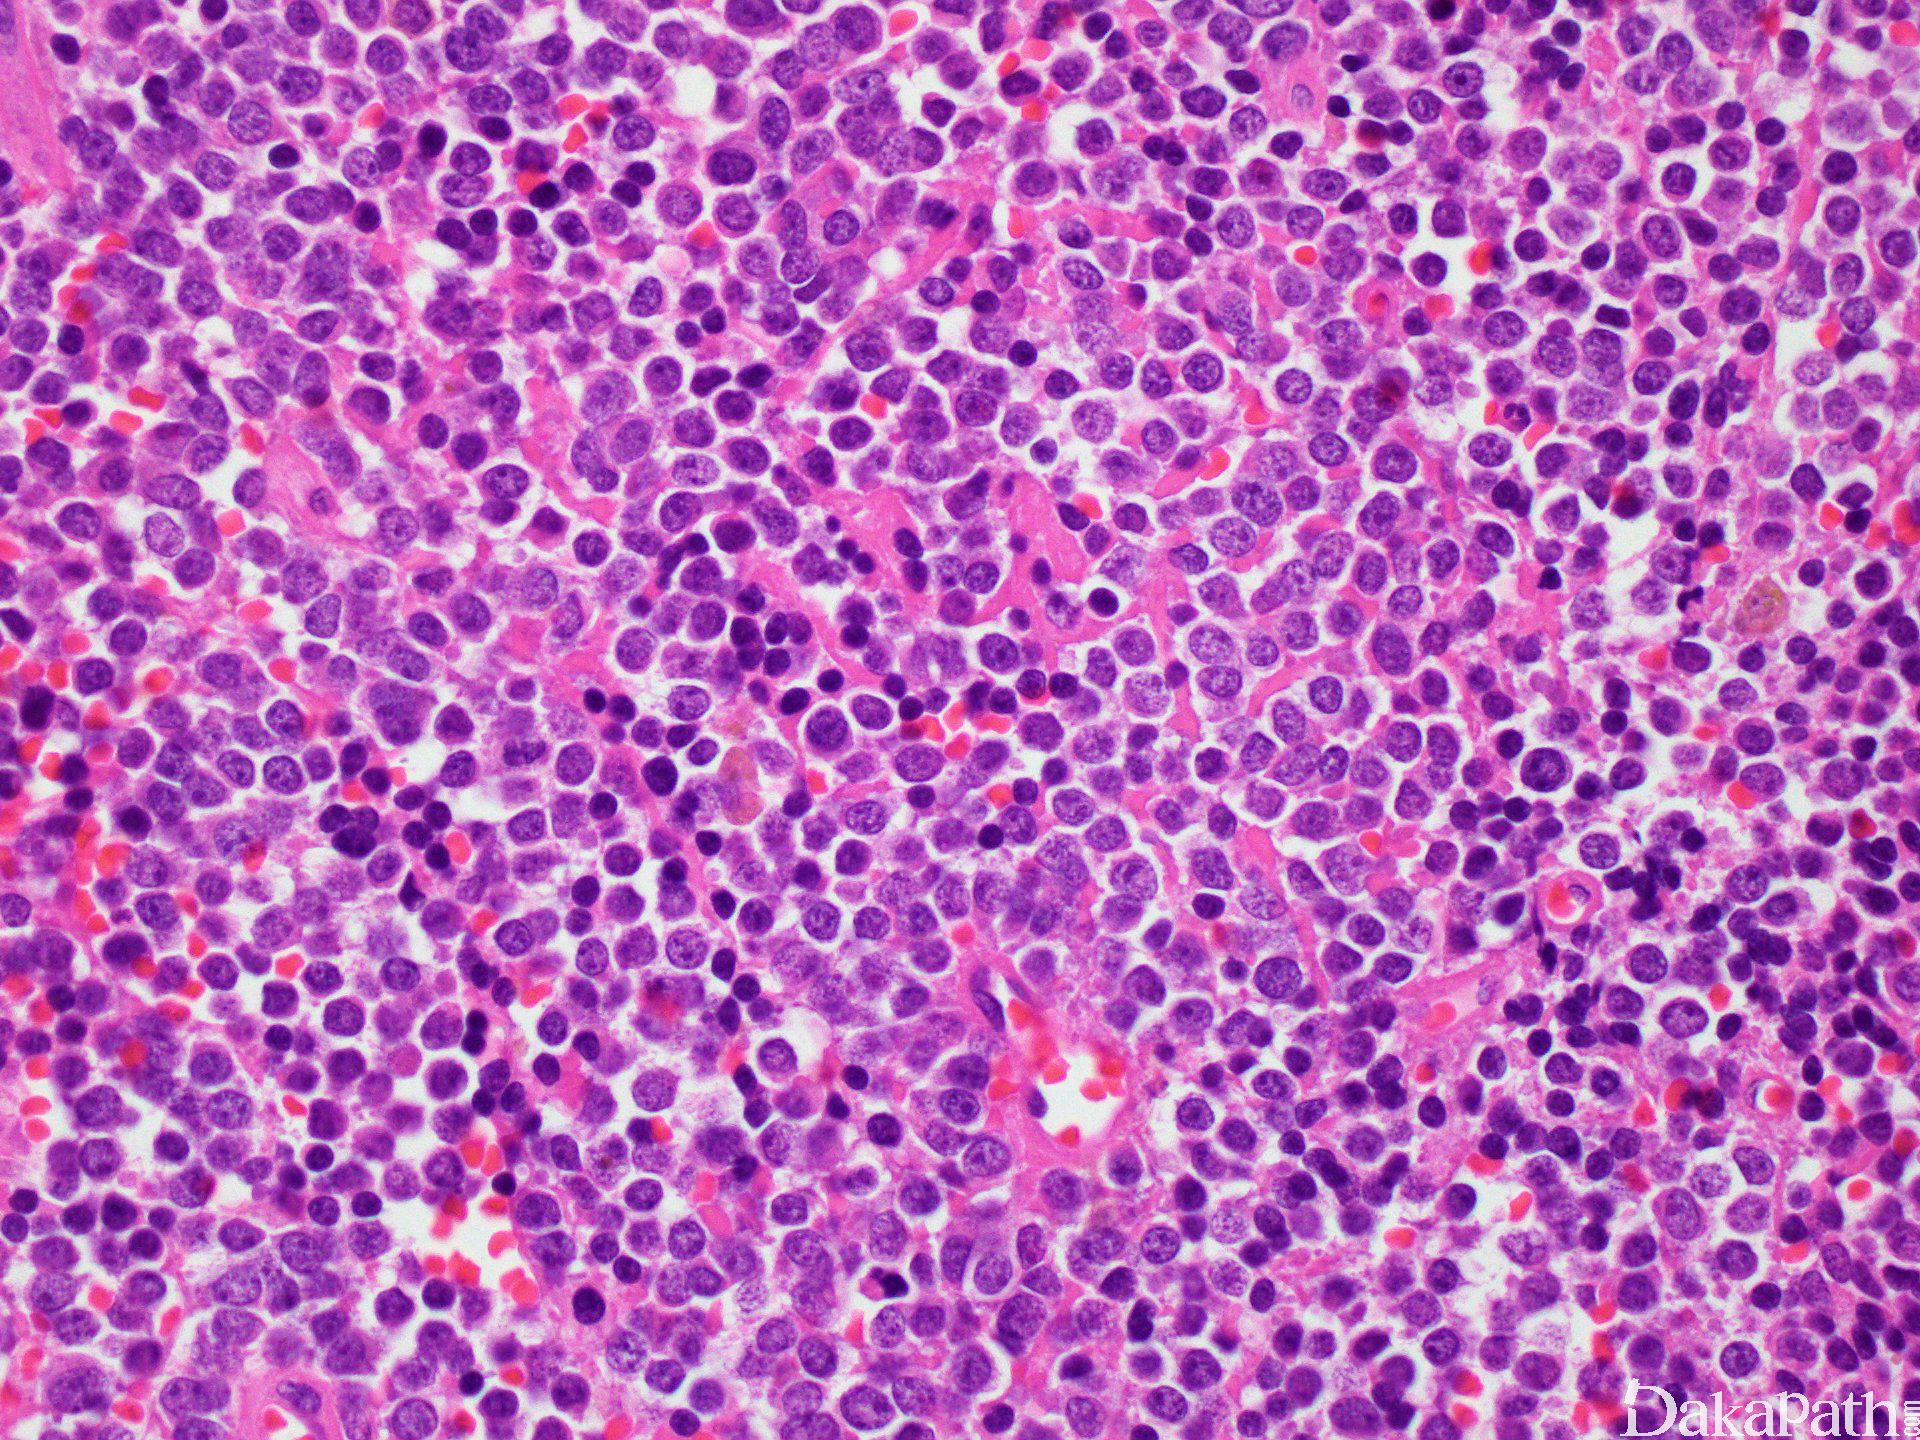

骨外尤文肉瘤
Extraskeletal Ewing’s Sarcoma
概述:
是骨外尤文肉瘤/外周原始神经外胚层瘤家族成员之一,是发生于软组织的小圆细胞肉瘤。
发病部位: 脊椎旁和胸壁,也可发生于下肢,少数位于盆腔、臀部、腹膜后和上肢
诊断要点:
EWS 好发于青年人,主要发生在脊椎旁和胸壁,常表现为软组织深部生长迅速的肿块;
大体检查呈多结节状或分叶状,常伴有出血、坏死及囊形变;
镜下见小圆细胞呈紧密成片或小叶状分布,小叶间为宽窄不等的纤维结缔组织间隔;
细胞胞质稀少或呈不规则小空泡状,PAS 染色阳性,可被淀粉酶消化;核形较规则,圆形或卵圆形,核膜清晰,核染色质细致、均匀,似粉尘样,核分裂像多少不等;部分病例细胞核可不规则,可见核折叠或核沟。
在 10%~ 20%的病例可见到 Homer-Wright 菊形团结构;
部分病例由小的暗细胞和中等大小的亮细胞混杂组成的双相性形态;暗细胞核深染、胞质稀少,似小淋巴细胞;亮细胞胞质相对丰富淡染,核染色质呈空泡状、似上皮细胞;组织挤压时暗细胞变性、扭曲呈细长梭形,似银丝样镶嵌于亮细胞巢周围,构成银丝状(filigree pattern),该结构常出现在血管丰富的区域或坏死性区域周围;
部分病例瘤细胞呈梁状或条束状排列,类似小细胞癌或类癌;
少数病例部区域可器官样、血管瘤样、腺泡状或呈血管外皮瘤样结构;
一些病例可见梭形细胞成分,类似恶性周围神经鞘膜瘤或纤维肉瘤;
间质血管丰富,瘤细胞可围绕血管生长形成乳头状结构;
肿瘤内常见凝固性坏死;
少数病例间质纤维结缔组织大量增生,而瘤细胞可呈巢状或宽梁状排列,易被误诊为促结缔组织增生性小圆细胞肿瘤;

免疫组织化学染色:
nkx2.2. vimentin 和 MIC-2(CD99)弥漫阳性,Fli-1. ERG 常阳性,NSE、Leu-7 和 SYN 部分病例阳性;S-100. NF 和 CgA 常阴性。
分子标记:
- 90%以上病例存在 t(11;22)(q24;q12),形成 EWS-FLI-1 融合基因;约 5%的病例存在 t(2 1;22)(q22;q12),形成 EWS-ERG 融合基因,<1%的病例存在 t(7;22)(p22;q 1 2),t(1 7;22)(q2 1;q1 2),t(2;22)(q33;q1 2),22q 倒置,t(1 6;21)(p 11;q22),并分别产生 EWS-ETV1. EWS-E1
鉴别诊断:
- 转移性 神经母细胞瘤 : 常伴节细胞分化,CD99. FLI-1. β-2 微球蛋白阴性,无 EWS-FLI-1 融合基因。
2**.腺泡状横纹肌肉瘤:** 通常能见到腺泡状结构,部分病例可见到横纹肌母细胞及核居周边分布的多核性巨细胞,desmin、MSA 和 myogenin 等多种肌细胞性标记阳性,FLI-1 常阴性,无 EWS-FLI-1 融合基因。
3**.滑膜肉瘤:** 多表达 AE/AE、CAM5.2 和 EMA,TLE3 阳性 SYT-SSX 阳性,EWS-FLI-1 阴性。
4**.淋巴母细胞瘤:** TDT 阳性。
预后:
取决于肿瘤的大小、部位以及临床分期。
治疗:
采用手术、放疗和化疗等综合性辅助治疗。
参考文献:
王坚,朱雄增. 软组织肿瘤病理学,第二版[M]. 人民卫生出版社,2017.
